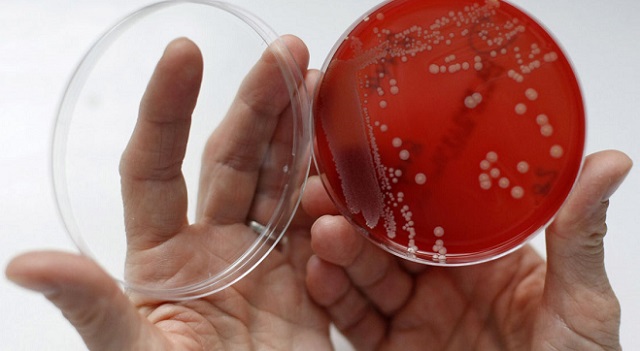
Бактериальный посев

Основные характеристики заболевания
Кандидоз бактериального типа – это форма молочницы, которая представляет собой самую распространенную гинекологическую проблему. Обратите внимание, что это заболевание не является самостоятельным, развиваясь на фоне той или иной патологии. Что же собой представляет данный вид молочницы? Бактериальный кандидоз характеризуется размножением условно-патогенных микроорганизмов на слизистой оболочке влагалища. То есть речь идет об увеличении количества «родных» бактерий, которые в норме составляют микрофлору. При воздействии предрасполагающих факторов они могут спровоцировать прогрессирование заболеваний гинекологической сферы.
Бактериальная форма кандидоза возникает в том случае, когда на слизистых оболочках влагалища преобладают гарднереллы. Другое название данного заболевания – гарднереллез. Следует понимать, что молочнокислые микроорганизмы, которые являются защитными, контролируют уровень всех бактерий, населяющих микрофлору. По тем или иным причинам, особенно когда снижается иммунитет, молочнокислых бактерий становится меньше. В этот период условно-патогенные микроорганизмы и начинают стремительно развиваться.
Плюс ко всему происходит увеличение количества дрожжеподобной среды, возбудителем которой являются грибки Candida albicans. Они так же, как и гарднереллы являются условно-патогенными микроорганизмами, которые находятся в организме всех женщин без исключения.
Бактериальный кандидоз отличается от обычной молочницы следующими признаками:
- Отсутствие усиления симптоматики в ночные часы.
- Наличие ярко выраженного неприятного «рыбного» запаха.
- Редкое появление отечности и гиперемии.
- Характер выделений – тягучесть, однородность, пенистость.
Вагинит представляет собой воспалительный процесс, источником которого являются бактерии. Они могут передаваться как половым путем, так и прогрессировать в организме самостоятельно на фоне определенных факторов.
Врачи отмечают, что бактериальный кандидоз представляет собой сложное заболевание, вызванное избыточным размножением грибов рода Candida на фоне бактериальной инфекции. Специалисты подчеркивают, что данное состояние часто возникает у пациентов с ослабленным иммунитетом, а также у тех, кто принимает антибиотики, что нарушает баланс микрофлоры. Симптомы могут варьироваться от зуда и жжения до выделений и воспаления. Врачи рекомендуют своевременно обращаться за медицинской помощью, так как игнорирование проблемы может привести к серьезным осложнениям. Лечение обычно включает противогрибковые препараты и восстановление нормальной микрофлоры. Важно также соблюдать гигиену и следить за состоянием здоровья, чтобы предотвратить рецидивы заболевания.

Что служит причиной вагиноза?
Кандидоз бактериального типа возникает в организме в следующих случаях:
- Проведение длительной или бесконтрольной антибактериальной терапии.
- Снижение защитных функций организма.
- Нарушение гормонального уровня организма (прием контрацептивов, беременность, дисфункции щитовидки и т. п.).
- Чрезмерное проведение спринцеваний и использование средств для подмывания, имеющих высокий уровень рН.
- Длительное использование гигиенических прокладок, которые являются отличной средой для размножения патогенных микроорганизмов.
- Нарушение микрофлоры кишечника.
- Ношение тесного синтетического белья.
Передаваться бактериальная форма кандидоза может при незащищенных половых актах, поэтому медикаментозное лечение половым партнерам следует проводить одновременно, что исключает вероятность развития рецидивов.
Как избежать развития заболевания?
Для того чтобы исключить вероятность развития бактериального кандидоза следует придерживаться элементарных правил профилактики:
- Принимать антибиотики только под контролем опытного врача.
- Делать перерывы в использовании гормональных контрацептивов.
- Своевременно лечить воспалительные процессы.
- Исключить из рациона сладкие продукты и сдобу.
- Спринцеваться по строгой схеме и только теми растворами, которые посоветовал врач.
- Не использовать ежедневные прокладки без необходимости.
- Носить только хлопчатобумажное свободное белье.
- Отказаться от приема алкогольных напитков.
Кроме того полезно включить в рацион достаточное количество овощей, фруктов и кисломолочной продукции, регулярно заниматься физическими упражнениями и постараться исключить стрессовые ситуации.
Особое внимание обратите на то, что к выбору половых партнеров следует относиться осмотрительно. Половые акты должны быть защищенными или же после сексуального контакта следует использовать антибактериальные суппозитории.
Бактериальный кандидоз — это тема, которая вызывает много обсуждений среди людей, столкнувшихся с этой проблемой. Многие отмечают, что симптомы, такие как зуд и дискомфорт, могут значительно ухудшить качество жизни. Некоторые делятся своими историями о том, как долго искали эффективное лечение, и как важно обратиться к врачу при первых признаках.
Мнения о причинах возникновения заболевания также различаются: кто-то связывает его с неправильным питанием, другие — с ослабленным иммунитетом или стрессом. В социальных сетях можно встретить советы по профилактике, включая рекомендации по поддержанию гигиены и укреплению иммунной системы.
Некоторые пользователи подчеркивают, что открытое обсуждение этой темы помогает снять стигму и облегчить страдания тех, кто сталкивается с кандидозом. В целом, люди стремятся делиться опытом и находить поддержку в сообществе, что делает эту проблему менее одиночной.

Постановка диагноза
Бактериальный вагиноз с молочницей имеют в некоторой степени схожую симптоматику, поэтому самостоятельно определить истинную причину появления выделений невозможно. Для этого нужно отправиться к гинекологу и сдать все необходимые анализы.
В обязательном порядке пациент сдает анализ на посев отделяемого на микрофлору. Чаще всего определяется кишечная палочка в высоком титре. Не исключено наличие и других условно-патогенных микроорганизмов. Данный возбудитель при отсутствии воздействия предрасполагающих факторов на организм самостоятельно не вызывает развитие воспалительного процесса. Подобное возможно только в том случае, когда в микрофлоре присутствует сразу несколько условно-патогенных микроорганизмов, которые вкупе с грибком Кандида увеличивают активность друг друга. В этом случае развития воспалительного процесса избежать не получится.
При выявлении ЗППП в обязательном порядке пациент направляется на консультацию к дерматовенерологу. Действенная медикаментозная терапия может быть назначена только профильным специалистом, знающим толк в данных делах.
Лечебные мероприятия
Бактериальную форму кандидоза ни в коем случае нельзя лечить самостоятельно. Для того чтобы подобрать наиболее эффективное медикаментозное средство, необходимо установить тип возбудителя заболевания, характер и стадию его течения. Поставить верный диагноз может только квалифицированный врач, опираясь на результаты проведенной диагностики.
В настоящее время на фармакологическом рынке представлено огромное количество антибактериальных и противогрибковых препаратов. Для каждого пациента подбирается индивидуальная медикаментозная терапия. В обязательном порядке назначаются укрепляющие иммунитет препараты, антигистаминные средства и восстанавливающие микрофлору суппозитории или растворы. Это позволяет комплексно воздействовать на проблему.
Эффективная тактика лечения:
Обработка слизистой оболочки для снятия воспалительного процесса и снижения выраженности симптоматики. Назначаются антисептические растворы и местные противогрибковые средства. Для этих целей, как правило, используют препараты, разработанные на основе флуконазола: Дифдюкан, Микомакс, Микосист, Флюкостат, Флуканазол. Самая эффективная форма – вагинальные суппозитории.
- Борьба с патогенными бактериями. Назначаются лекарства с метронидазолом: Клион, Метровагин, Трихопол, Метрогил. Препараты, в
составе которых имеется данный активный компонент, не только приводят в норму количество условно-патогенных микроорганизмов, но и помогают вылечить сопутствующие заболевания, восстанавливая местный иммунитет. Для того чтобы исключить вероятность рецидивов следует принять меры для поддержания микрофлоры.Для восстановления влагалищной микрофлоры используются такие препараты, как «Вагинорм-С», «Лактогин» и «Нормофлорин».
При бактериальном кандидозе лечение должно проводиться комплексно, то есть одновременно нужно принять меры для уничтожения бактерий и грибка, а также для восстановления микрофлоры влагалища. Длительность использования препаратов, разработанных на основе метронидазола и флуконазола не должна быть более 7 дней. В редких случаях терапия продолжается в течение 2 недель.
Антибактериальная терапия при беременности

В данном случае используются только те препараты, которые предназначены для локального нанесения на проблемный участок слизистой оболочки. При беременности лучше всего принять меры, направленные на восстановление естественной микрофлоры влагалища. Молочнокислые организмы вытесняют болезнетворные бактерии, снимая симптоматику и нормализуя естественную микрофлору влагалища.
Бактериальный кандидоз достаточно сложно выявить, а уж тем более вылечить. Ни в коем случае нельзя заниматься самодиагностикой и самостоятельно использовать лекарственные препараты. Это чревато развитием серьезных осложнений. При появлении первичной симптоматики заболеваний гинекологической сферы следует незамедлительно проконсультироваться со специалистом.

Вопрос-ответ
Что такое бактериальный кандидоз и как он возникает?
Бактериальный кандидоз — это инфекционное заболевание, вызванное избыточным ростом грибов рода Candida, которые обычно присутствуют в организме человека в небольших количествах. Он может возникнуть при ослаблении иммунной системы, длительном применении антибиотиков, нарушении микрофлоры или при наличии хронических заболеваний.
Какие симптомы характерны для бактериального кандидоза?
Симптомы бактериального кандидоза могут варьироваться в зависимости от места инфекции, но часто включают зуд, жжение, белый налет на слизистых оболочках, покраснение и отек. У женщин могут наблюдаться выделения из влагалища, а у мужчин — воспаление головки полового члена.
Как лечится бактериальный кандидоз?
Лечение бактериального кандидоза обычно включает противогрибковые препараты, которые могут быть назначены в виде таблеток, кремов или суппозиториев. Также важно восстановить нормальную микрофлору организма, что может потребовать изменения диеты и применения пробиотиков. Важно обратиться к врачу для получения индивидуальных рекомендаций и назначения лечения.
Советы
СОВЕТ №1
Регулярно проходите медицинские обследования. Это поможет выявить бактериальный кандидоз на ранних стадиях и предотвратить его развитие. Обсуждайте с врачом любые изменения в вашем здоровье, особенно если вы замечаете симптомы, такие как зуд или необычные выделения.
СОВЕТ №2
Соблюдайте правила личной гигиены. Регулярное мытье и поддержание чистоты в области гениталий поможет предотвратить размножение грибков и бактерий. Используйте мягкие, неароматизированные средства для интимной гигиены.
СОВЕТ №3
Обратите внимание на свой рацион. Употребление большого количества сахара и углеводов может способствовать росту грибков. Включите в свой рацион больше овощей, фруктов и пробиотиков, которые помогут поддерживать здоровую микрофлору.
СОВЕТ №4
Избегайте самодиагностики и самолечения. Если у вас есть подозрения на бактериальный кандидоз, обратитесь к врачу для получения точного диагноза и назначения соответствующего лечения. Неправильное лечение может усугубить проблему.



Обработка слизистой оболочки для снятия воспалительного процесса и снижения выраженности симптоматики. Назначаются антисептические растворы и местные противогрибковые средства. Для этих целей, как правило, используют препараты, разработанные на основе флуконазола: Дифдюкан, Микомакс, Микосист, Флюкостат, Флуканазол. Самая эффективная форма – вагинальные суппозитории.
составе которых имеется данный активный компонент, не только приводят в норму количество условно-патогенных микроорганизмов, но и помогают вылечить сопутствующие заболевания, восстанавливая местный иммунитет. Для того чтобы исключить вероятность рецидивов следует принять меры для поддержания микрофлоры.Для восстановления влагалищной микрофлоры используются такие препараты, как «Вагинорм-С», «Лактогин» и «Нормофлорин».
